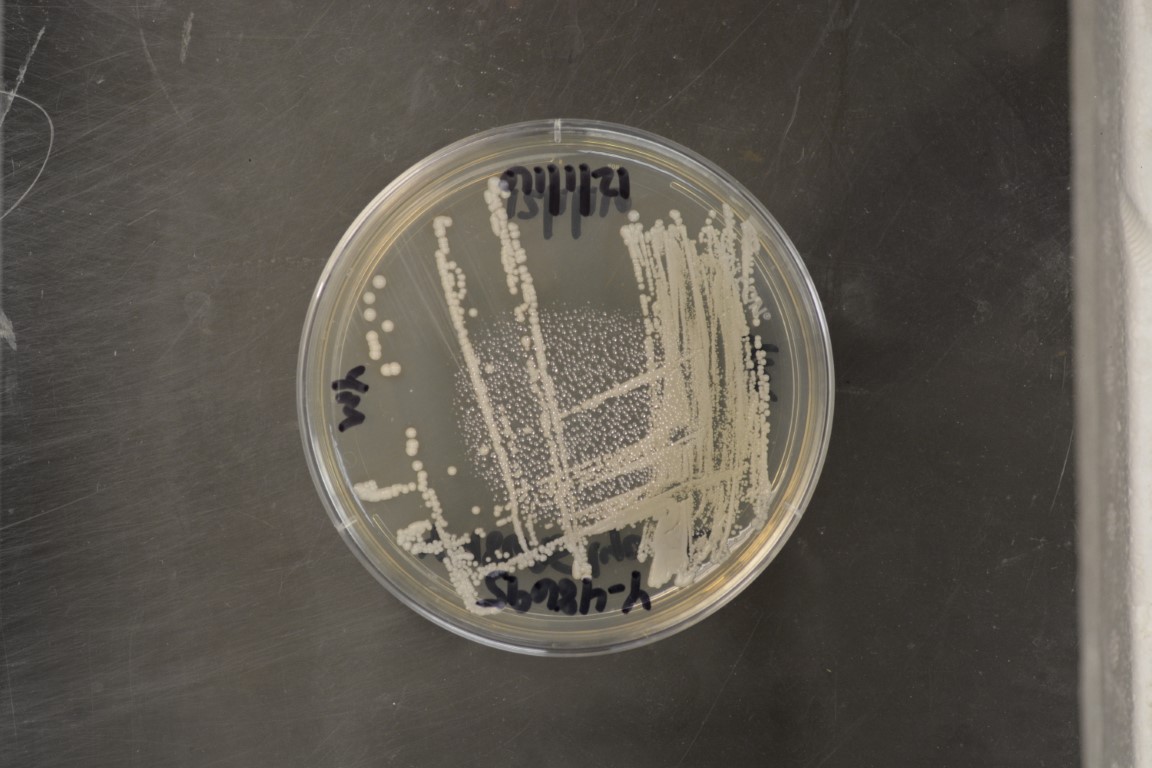

Metschnikowia andauensis
NRRL Y-48695(Type Strain)
Accession numbers in other collections:CBS 10809=HA 1657
Source:Hansjoerg Prillinger,Universail fur Bodenkulture
Isolated from(substrate):IN,gut of a caterpillar of a moth,Helicoverpa armigera on corn
Substrate location:Vienna,Austria
Genetic info:GenBank:D1/D2(AJ745110),Actin 1(AJ745122).
Growth media:Yeast Extract-Malt Extract-Peptone-Glucose(YM for yeasts)(number 6)
Optimum growth temperature:25C
Strain images:
NRRL_Y-48695_6.JPG